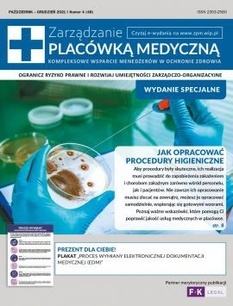

Dziękujemy za wypełnienie formularza.
Uwaga: Drogi Czytelniku, na Twój adres email została wysłana wiadomość - Sprawdź swoją pocztę elektroniczną.
Jeśli wiadomości nie ma w głównym folderze, zajrzyj do zakładki spam, zakładki oferta lub innych katalogów.
Otwórz wiadomość, kliknij w znajdujący się w niej link i pobierz numer specjalny magazynu „Zarządzanie placówką medyczną”.